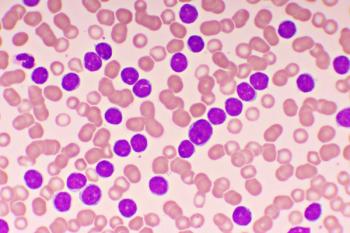

Treatment options are distinct in their mechanisms, safety profiles, and implications for patients’ quality of life.
Treatment options are distinct in their mechanisms, safety profiles, and implications for patients’ quality of life.

In crafting a patient-centered regimen, the convergence of expertise from physicians and pharmacists, paired with the values and preferences of patients, becomes paramount.

The role of monoclonal antibodies in minimizing COVID-19–related complications remains important to assess.

Published: April 12th 2023 | Updated: